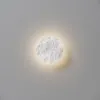

Пн-Вс: c 9:00 до 18:00
заказать звонок
Бра Maytoni MOD461WL-L5GRK
10 560
3
Информация о доставке
Доставка по Москве, пределах МКАД
- Доставим бесплатно
- Смотреть тарифы подробнее
Доставка по МО, за пределы МКАД
Бесплатно, до 15км от МКАД
Бесплатный Самовывоз
- г. Москва, Дмитровское шоссе д.100с2
Доставка по всей России
- Отправим заказ любой транспортной компанией
Характеристики
Модель
MOD461WL-L5GRK
Остаток
3
Производитель
Стиль
Коллекция
Способ крепления
Цвет свечения
Цветопередача
Плафон
Угол рассеивания света
180
Плафон
Форма плафона
Арматура
Размеры
Ширина/диаметр
150
Высота
150
Площадь освещения
1
Мощность общая
5
Лампы
Тип лампы
Коробка
Объем коробки
0.01
Вес коробки
1.55
Размер коробки (ДхШхВ)
240х240х135
Другие товары коллекции
С этим товаром покупают
Лампочки

Telegram
Telegram Вконтакте
Вконтакте Facebook
Facebook Instagram
Instagram